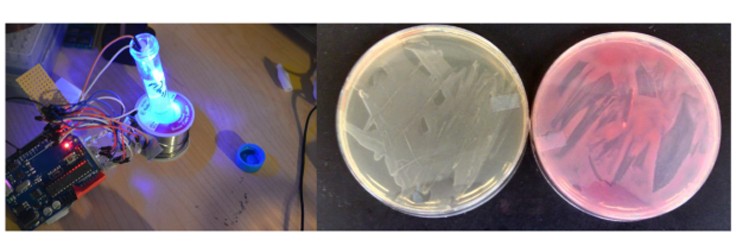
The ODIN

Bioeconomy Policy
A Day in the Life of Josiah Zayner, The Open Discovery Institute’s Iconoclast CEO
Dec 17, 2015
“If you had access to cutting edge synthetic biology tools, what would you create?” asks Josiah Zayner, CEO of the Open Discovery Institute (a.k.a The ODIN), a new startup that seeks to bring synthetic biology out of the lab and into the house. Just as the advent of the personal computer spawned a movement of independent enthusiasts developing new technology by improving upon what was currently available, Zayer and the ODIN are part of a wider network of people interested in BioHacking or Do It Yourself (DIY) Biology, who seek to follow in the footsteps of computer hackers.The idea is that by making synthetic biology readily accessible to anyone who has an interest, personal creativity and sheer numbers can invoke massive progress and lead to new biotechnology. Zayner put it to me this way “Did you expect that one of the predominant operating systems in the world would be created by a Master's student in Finland hacking code in his free time? Or would you have said Bell Labs or MIT? I think the future of Science will be in the hands of people at home.”
So that all sounds well and good. More people becoming interested and empowered to do synthetic biology would certainly be a boon for the field, and the track record of small collectives making enormous contributions to computing hardware and software is undeniable. But isn’t biology different? Don’t you need a lab, expensive equipment and graduate students? Is it even possible to do Science without perpetually worrying about grant money? Zayner’s answers to these questions are a resounding and unequivocal “No!” And that’s where his company comes in.
On The ODIN you can purchase all the lab equipment you need to start doing basic synthetic biology right in your kitchen or garage for a couple hundred bucks. They’ve got PCR machines for just $150, pipettes, CRISPR kits for bacteria and yeast starting just over $100 and much more. Zayner himself runs his own experiments from home, a tradition he started back in graduate school to circumvent his advisor’s refusal to pursue certain projects.
An optogenetics ODIN kit for light-controlled bacteria. Proteins that respond to blue light can be used to engineer changes in gene expression or to affect signaling cascades.The ODIN seems to be imbued with a typical hacker ethic; rejection of rigid authority structures, passion for one’s work, open access to information and a desire to break the rules. Zayner himself seems to perfectly embody these principles. He’s a guy who thinks that practicing Science (that’s capital ‘S’ Science as he always types it!) shouldn’t be open to only a privileged class at universities and research centers. He believes ordinary people can help change the world by starting research projects in their own homes. He’s motivated by trying to help others exercise creativity through Science. So to get a better feel for the spirit of what The ODIN is all about, Josiah Zayner walked me through his typical daily schedule as the CEO and a biohacker himself.
Morning
Zayner starts his morning roughly at 8 AM, and after a small meal and a coffee gets straight to work. He plunges head first into one of his most time consuming responsibilities: emails. “I spend so much time on emails, maybe sometimes too much time. I interact with people so they know that The ODIN is not just some nondescript behemoth trying to make money, it's much more. Out of the hundreds of customers that The ODIN has had, I have personally emailed every one of them to understand their Scientific goals and how The ODIN can help them achieve those goals.”Indeed, this sense of community is the most salient feature of The ODIN. Zayner said he even tries to go the extra mile when he can, “I try and customize each order by providing extra materials that I think the person might need to accomplish their experiments.” He elaborated on the importance of such gestures even further: “Science is not really a product, it requires community, collaboration and discussion. If BioHacking and DIY Science is to succeed outside of academia and industry it is going to need communication between all parties involved. Dissemination of information and knowledge is the fundamental point of Science.” The packing involved with processing incoming orders usually commences after emails and takes him to lunch in the early afternoon.
Lunchtime
Although Zayner works hard, he doesn’t discount the benefit of leisure and takes time to make lunch and unwind in the middle of the day. He explained “Though I think it is important to work, I think it is even more important to be comfortable. Working 80 hours a week will not make my company function better (though I often work on weekends answering emails and shipping things if needs be). What will make my company function better is well thought out and focused actions. Anyone who has done a start-up or gone to graduate school and grinded out 70 or 80 hour weeks knows that at a certain point, productivity declines, no matter if it is the most menial job or the most intellectual.” Rest might be a foreign concept to certain startups, but Zayner thinks it is critical to success and is unperturbed by what everyone else is doing. “I set aside a period of at least 15 minutes each day that I just relax and think. The current generation of entrepreneurs is so focused on accomplishing things that they don't often think things through completely.”
Afternoon
Having recharged his system, Zayner predominantly spends his afternoons doing Science himself, but also (surprise, surprise) answering more emails. He described this as his favorite time of the day, because he gets to indulge in his passion. “The best thing about The ODIN is that I am still able to do Science. The whole reason the company was started was so that I could help other people experience how amazing Science is.” His research spans everything from experimental work for making highly functional kits for The ODIN to theoretical musings on how best to accomplish genetic encryption. Some days of the week he takes time out to teach at biohacker centers such as Counter Culture Labs in Oakland, CA. He added “Though I don't know if it counts as part of my "job", I somewhat consider my "job" my life. My life goal is to do Science and help other people be able to do Science. Whether I had a business or not, I would still be doing those two things so it is great that my goals are also the goals of business (weird how it can work that way when you start a business).” It’s a common thread with Zayner and The ODIN: do what you love (in Science).He ends his nights “with a beer and some whiskey (Laphroaig 10 year). Makes sure any cultures and plates are put away or incubating at the correct temperature and goes to sleep.”So there it is, a day in the life of The ODIN’s iconoclast CEO Josiah Zayner. If you like the way Zayner and The ODIN go about Science you can start doing your own synthetic biology projects at home by simply going to http://www.the-odin.com/about/


















